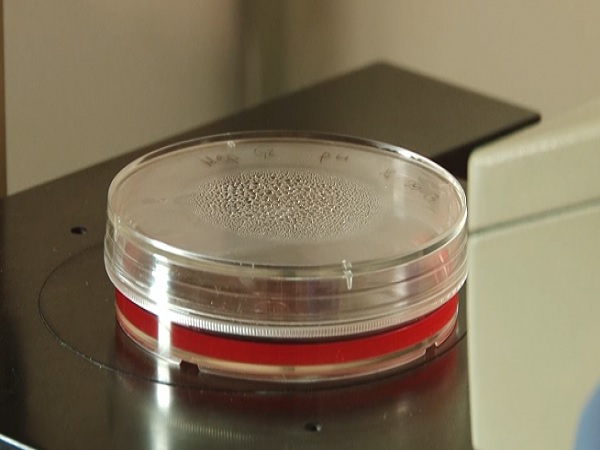
Płytka Petriego z czerwonym agarem i kondensacją na pokrywce

Patogeny grzybowe śmiertelnie niebezpieczne. Przez globalne ocieplenie coraz lepiej radzą sobie w wysokich temperaturach, alarmują eksperci.
Według różnych źródeł infekcje grzybicze mogą powodować 1,3–1,7 mln zgonów rocznie, a pośrednio przyczyniać się do kolejnych kilku milionów zgonów. Z 250 tys. znanych gatunków grzybów 200 jest patogennych. Niektóre są jednak tak groźne, że według WHO mogą spowodować problemy w systemach ochrony zdrowia. Jesienią ubiegłego roku organizacja opublikowała listę 19 najniebezpieczniejszych rodzajów mykopatogenów. Rozwojowi mutacji patogenów grzybowych sprzyja globalne ocieplenie, które wzmacnia mechanizmy adaptacyjne i uodparnia je na wysokie temperatury. Niektóre z grzybów mogą mutować podczas infekcji, w warunkach termicznych ludzkiego organizmu.
O temacie chorobotwórczych grzybów zrobiło się ostatnio głośno dzięki serialowi „The Last of Us”, w którym przedstawiono wizję apokalipsy zombie wywołanej właśnie przez grzyba o nazwie Cordyceps, przystosowanego do przetrwania w wysokich temperaturach. O tym problemie mykolodzy alarmują od lat. Podkreślają jednocześnie, że zdecydowana większość grzybów występujących w środowisku naturalnym nie ma potencjału chorobotwórczego dla ludzi, ponieważ nie jest w stanie przetrwać w temperaturze, jaka panuje w ludzkim ciele. Takiej „tarczy ochronnej” nie mają rośliny, które często padają ofiarą grzybów. Jednak eksperci przestrzegają, że ta sytuacja może się stopniowo zmieniać.
– Mykolodzy mają obawy dotyczące pojawienia się wskutek globalnego ocieplenia grzybów, które są odporniejsze na wysokie temperatury. Potencjał chorobotwórczy mają tylko te grzyby, które są w stanie przetrwać w temperaturze ciała człowieka. Wzrost zachorowań na inwazyjne infekcje spowodowane grzybami wynika w dużej mierze z tego, że jest coraz więcej ludzi z osłabionym układem odpornościowym lub chorobami współistniejącymi – mówi w wywiadzie dla agencji Newseria Innowacje dr Asiya Gusa z Wydziału Genetyki Molekularnej i Mikrobiologii Duke University w Durham, uczestniczka programu ASBMB w ramach projektu MOSAIC.
Pod koniec ubiegłego roku WHO opublikowała listę priorytetowych patogenów grzybiczych. Znajdują się na niej mikroorganizmy, które zdaniem ekspertów mogą powodować poważne problemy dla systemów ochrony zdrowia. Jednym z najbardziej krytycznych patogenów jest Cryptococcus neoformans, wywołujący kryptokokozę ośrodkowego układu nerwowego. Choroba może prowadzić do zapalenia opon mózgowych.
– Cryptococcus to najbardziej zabójczy dla ludzi patogen grzybowy. Na zakażenie tym grzybem narażone są głównie osoby o osłabionym układzie odpornościowym (chorzy na AIDS lub biorcy przeszczepu) i cierpiące na choroby współistniejące. Coraz częściej jednak odnotowuje się przypadki infekcji u osób zdrowych. Infekcje tym grzybem prowadzą do ponad 110 tys. zgonów rocznie, a ponadto odpowiadają za ponad 19 proc. zgonów powiązanych z HIV i AIDS – podkreśla dr Asiya Gusa.
Z badania naukowców z Duke University, którego rezultaty zostały opublikowane w styczniu na łamach czasopisma naukowego „PNAS”, wynika, że w warunkach wyższych temperatur w grzybach zachodzą szybsze zmiany genetyczne. Można więc się spodziewać, że rosnące globalne temperatury i zmiany klimatu spowodują nasilenie chorób grzybiczych u roślin i ssaków. Szczególnie niepokojące jest jednak to, że mutacje nasilają się w temperaturze zbliżonej do tej w ludzkim organizmie, co może mieć wpływ na cięższy przebieg infekcji u ludzi.
– Badanie polegało na prostym eksperymencie z hodowlą interesującego nas grzyba w dwóch różnych temperaturach. Przyjrzeliśmy się jego wzrostowi przez kilka pokoleń (ok. 100 dni) w temperaturze 37 st. C , a więc zbliżonej do tej, która panuje w ludzkim ciele, oraz 30 st. C, czyli temperaturze zazwyczaj stosowanej w warunkach hodowli laboratoryjnej. W wyższej temperaturze nasilały się mutacje spowodowane przez transpozony, potocznie zwane „skaczącymi genami” – podkreśla badaczka.
Jak zauważa, „skaczące geny” mogą powodować zmiany ekspresji genów grzyba, potencjalnie uruchamiając mechanizmy adaptacyjno-ewolucyjne. Chodzi m.in. o lekooporność czy wzmacnianie cech, które zwiększają potencjał chorobotwórczy, np. termotolerancję.
– Zaobserwowaliśmy, że w wyższej temperaturze nastąpił pięciokrotny wzrost prawdopodobieństwa wystąpienia mutacji wywołanych tymi genami – mówi dr Asiya Gusa.
Szczególne trudności w leczeniu zakażeń grzybiczych wynikają ze wspomnianej już lekooporności. Problemem jest też wysokie podobieństwo komórek grzybiczych do ludzkich, które utrudnia dobór terapii. Nie ma też szczepionek, które mogłyby zapewnić populacyjną odporność na infekcje.
Jak zaznacza ekspertka, wyniki badań oznaczają, że w następstwie coraz wyższych temperatur ewolucja grzybów może przebiegać szybciej, niż wcześniej sądzono. Chociaż nie są to organizmy, które przechodzą z osoby na osobę, to przedostają się do ludzkiego ciała równie łatwo, przez wdychane powietrze. Dlatego potrzebne są dalsze badania nad rozprzestrzenianiem się chorób grzybiczych i nowymi lekami przeciwgrzybiczymi, a także potencjalnymi szczepionkami.
(Newseria)